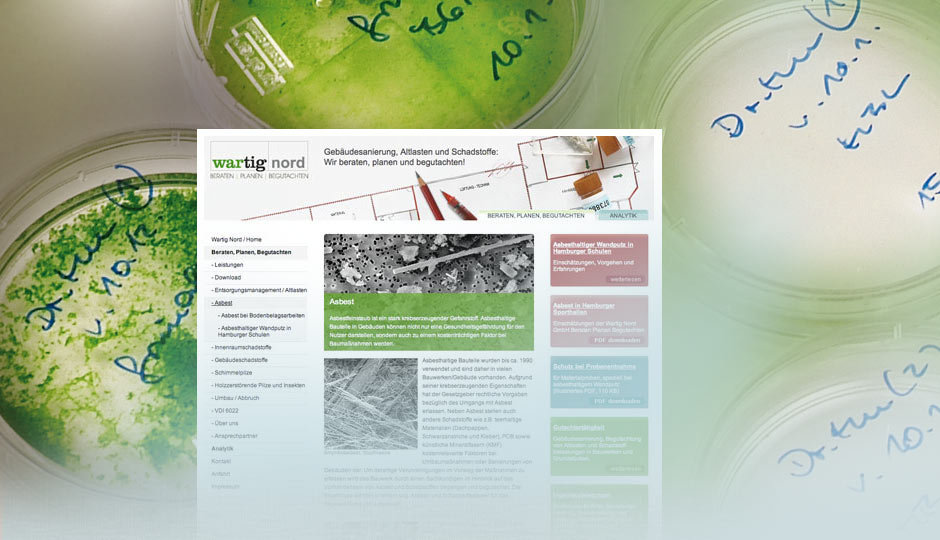

BUILT IN ST. PAULI ist ein innovatives Büro- und Geschäftshaus, das bis 2019 zwischen Rindermarkthalle und Neuer Pferdemarkt an der Budapester Straße in Hamburg entsteht. Weiterlesen...

Pünktlich zum Geburtstag der SLV Nord präsentiert sich die Webseite im neuen Design: mit verbesserter Struktur, optisch moderner und mit neuen Inhalten und neuem Bildmaterial. Weiterlesen...

Eine Webseite für den neuen innovativen und urbanen Gewerbe- und Handwerkerhof »Built in Barmbek« am Holsteinischen Kamp. Weiterlesen...

Gestaltung einer neuen Tafel für die Wanderausstellung „Demokratie stärken – Rechtsextremismus bekämpfen“. Weiterlesen...

Der Elbkulturfonds wurde 2013 ins Leben gerufen, mit dem Ziel Projekte von hoher inhaltlicher und künstlerischer Qualität in Konzeption und Umsetzung zu fördern. Weiterlesen...

Das Photoblog Poly24 ist das Fotoalbum von Ingrid Völlmeke. Seit 2004 wurden schon über 1.300 Fotografien online gestellt. Weiterlesen...

Wilma – ein Neubauprojekt im Hamburger Süden – bietet Raum für unterschiedliche Wohn- und Arbeitsformen. Weiterlesen...

Eine ganz neue Form von Stadtentwicklung: Das »Bündnis für Quartiere«. Im Frühjahr 2015 wurde das Bündnis für die beiden Pilotgebiete Rothenburgsort und südliches Hamm von 14 Unternehmen der Wohnungswirtschaft und dem Bezirksamt Hamburg-Mitte gemeinsam gegründet. Weiterlesen...

Unterrichtsmaterialien in einem anspruchsvollem Layout für die Hamburger Stiftung für Wirtschaftsethik – gekonnt umgesetzt und geliefert als InDesign-Template. Weiterlesen...

Für das Bezirksamt Hamburg-Nord wurde eine Webseite für das Bürgerhaus in Langenhorn erstellt. Weiterlesen...

Ruth Winnefeld berät und coached Unternehmen und Privatpersonen im beruflichen und persönlichen Bereich. Die neu erstellte Webseite präsentiert die Schwerpunkte ihres Angebotes klar und strukturiert. Weiterlesen...

Die Friedrich-Ebert-Stiftung lädt junge Menschen bis 35 Jahre aus Norddeutschland zu diesem Inselseminar ein. Thema: Werte, Ideale und Zukunft sozialer Demokratie. Weiterlesen...

Blinde schicken ihre Bilder, die Autoren dann beschreiben. Als Service. Nicht nur für Blinde, weltweit. Umgesetzt mit Wordpress. Weiterlesen...

Die Meistermeile bietet rund 70 kleinen und mittleren Handwerks- und Produktionsbetrieben Gewerbeflächen zu fairen Mietpreisen an. Weiterlesen...

Mit einem Fokus auf digitale Medien bietet das Eifflerwerk Kleinstbüros und großzügigen Creative Space für Start-Ups in der Schanze. Weiterlesen...

… und professionelle Übersetzungsdienste. Dazu: Hochgebirge, Seenlandschaften, Ostseeküste mit Zuckerbäckerstränden oder Kurorte – für jeden Polen-Liebhaber ist etwas dabei. Auf mehreren tausend Seiten. Weiterlesen...

Für die „Integrierte Stadtteilentwicklung“ in Altona-Altstadt wurde eine „dreifache“ Webseite gestaltet und umgesetzt: Altona-Altstadt, Fördergebiet „Soziale Stadt“ und Sanierungs- und Stadtumbaugebiet Altona-Altstadt S5 - Große Bergstraße/Nobistor. Weiterlesen...

Die Friedrich-Ebert-Stiftung ist die älteste politische Stiftung in Deutschland. Und das Julius-Leber-Forum das Regionalbüro für die Bundesländer Bremen, Hamburg und Schleswig-Holstein. Für die Veranstaltungen der politischen Bildung gestaltet IconScreen die Einladungs-Flyer. Weiterlesen...

Die am häufigsten gezeigte Ausstellung gegen Rechts in Deutschland – initiiert von der der Friedrich-Ebert-Stiftung – wurde von uns für Rumänien überarbeitet und neu gestaltet. Die Umsetzung erfolgte in Kooperation mit dem Elie-Wiesel-Institut zur Erforschung des Holocaust (INSHR EW) in Bukarest. Weiterlesen...

Der neue datenbankbasierte Webauftritt verwaltet und präsentiert eine Vielzahl von Informationen rund ums Thema Schweißtechnik und gibt einen Überblick über die umfangreichen Lehrgangs- und Seminarangebote der SLV Nord. Und das Beste: Alle Lehrgangsangebote sind auch online zu buchen! Weiterlesen...

Der gemeinnützige Träger heilende Stadt betrachtet Städte als Orte, die der ganzheitlichen Heilung von Körper, Geist und Seele dienen. Heilende Stadt initiiert zukunftsweisende und gesundheitsfördernde Projekte und Angebote, die Naturverbindung, Gemeinschaftsbildung und bürgerschaftliches Engagement in öffentlichen Parks und Grünanlagen ermöglichen. Weiterlesen...

Im Hamburger Süden soll die Wilhelmsburger Reichsstraße um einige hundert Meter weiter in eine bestehende Bahntrasse verlegt und mit mehreren hohen Lärmschutzwänden versehen werden. Dadurch soll eine große Verkehrsachse weniger den Stadtteil durchschneiden. Weiterlesen...

Die neue Webseite zur Überdeckelung der A 7 im Hamburger Stadtgebiet bietet Informationen zur Erweiterung der Bundesautobahn und zu einem der größten Lärmschutzprojekte Deutschlands. Weiterlesen...

Für die Hamburger Parkanlage »Planten un Blomen« wurde eine bildhafte und informative Webseite gestaltet und umgesetzt. Weiterlesen...

Die von der steg treuhänderisch verwalteten Gebäude im Hamburger Gängeviertel sollen in den kommenden Jahren mit öffentlicher Förderung saniert und gesichert werden. Weiterlesen...

Vielfältige Themen zur politischen Bildung: Das Julius-Leber-Forum der Friedrich-Ebert-Stiftung lädt ein. Die Flyer sind von IconScreen gestaltet. Weiterlesen...

Um das Gebiet Bergedorf Süd, im Osten von Hamburg, attraktiver zu machen, greifen verschiedene Stadtentwicklungsprogramme ineinander und werden im Auftrag des Bezirksamtes Hamburg Bergedorf und der Behörde für Stadtentwicklung und Umwelt der Stadt Hamburg umgesetzt. Weiterlesen...

„Das ist die am häufigsten gezeigte Ausstellung gegen Rechts in Deutschland“, Frederic Werner von der Friedrich-Ebert-Stiftung zu der Wanderausstellung „Demokratie stärken – Rechtsextremismus bekämpfen“. Weiterlesen...

Eine einfache und informative Website für die neuen Gründeretagen in der Großen Freiheit (Hamburg) im »OnePage Design«. Sämtliche Inhalte der Website sind schnell und einfach zugänglich. Die Website ist für verschiedene mobile Geräte und Desktop-PCs per RWD (Responsive Web Design) optimiert. Weiterlesen...

Die Website »via-bus« sollte mit dem Redaktionssystem CoreMedia innerhalb der Domain »hamburg.de« neu erstellt werden. Dazu wurde das vorgegebene Kommunikationsmuster, welches das Layout der Seite definiert, genutzt. In diesem Rahmen wurde eine attraktive und übersichtliche Gestaltung der Website umgesetzt. Weiterlesen...

Für die steg Hamburg, den größten Sanierungsträger und Quartiersentwickler Norddeutschlands, hat IconScreen das Webdesign neu entworfen und umgesetzt. Weiterlesen...

Schick verpackt im Norden – die Einladungen zu den Veranstaltungen zur politischen Bildung des Julius-Leber-Forums: Das Regionalbüro der Friedrich-Ebert-Stiftung für die Bundesländer Bremen, Hamburg und Schleswig-Holstein. Weiterlesen...

Seit Januar 2010 hat die steg Stadterneuerungs- und Stadtentwicklungsgesellschaft NRW mbH als Tochterunternehmen der steg Hamburg mbH ihren festen Sitz in der Dortmunder Innenstadt. Die steg NRW berät Kommunen, Wohnungsunternehmen und private Kunden. Weiterlesen...

Online Informationen zum Quartiersmanagement: Das Fördergebiet, welches den Langenhorner Markt und die Südliche Tangstedter Landstraße umfasst, ist gesellschaftlicher Mittelpunkt des Stadtteils Langenhorn mit seinen ca. 40.000 Einwohnern im Bezirk Hamburg-Nord. Weiterlesen...

Klar, Responsives Design* müssen wir auch nutzen: Was lag also näher als mit unserer eigenen WebSite zu beginnen und unsere Fähigkeiten zu trainieren. Herausgekommen ist ein Design, dass sich den verschiedenen Geräten anpasst. Egal ob die User einen Desktop-PC, ein Smartphone oder einen Tablet-PC nutzen. Die Darstellung auf diesen Geräten unterscheidet sich durchaus voneinander, aber das „Look and Feel“ bleibt erhalten. Weiterlesen...

„Wir müssen mit dem Vergeben beginnen – Ernst Paul: Böhme, Deutscher, Europäer“ (1897 – 1978): Die Ausstellung schildert exemplarisch am Leben Ernst Pauls die Geschichte der sudentendeutschen Arbeiterbewegung. Die 16 Tableaus dokumentieren seinen politischen Werdegang, seine Vision einer deutsch-tschechischen Partnerschaft und einem gemeinsamen Europa. IconScreen gibt der in zwei Sprachen erstellten Ausstellung ein durchgängiges Design. Ein Katalog begleitet die Ausstellung. Weiterlesen...

Es ist das Ziel des Hamburger Senats, der Universität Hamburg und des Bezirks Eimsbüttel, die Universität in den kommenden Jahren am Standort in Eimsbüttel umfassend zu erneuern und auszubauen. Diese WebSite begleitet den Prozess. Realisiert im Kommunikationsmuster der Stadt Hamburg. Weiterlesen...

Auch im „verflixten 7. Jahr“ macht es nach wie vor große Freude zu den interessanten Veranstaltungen des Julius-Leber-Forums die passende Einladung zu gestalten. Weiterlesen...

Für die Wanderausstellung „Demokratie stärken – Rechtsextremismus bekämpfen“ des Julius-Leber-Forums erstellte IconScreen die grafische Grundkonzeption. Herausgekommen ist eine sehenswerte Wanderausstellung gegen Rechtsextremismus, die erfolgreich in den vergangenen Jahren gezeigt wurde. Begleitend zur Ausstellung erschien eine Broschüre mit 52 Seiten. Weiterlesen...

Im September 2010 öffneten Künstlerinnen und Künstler sowie Galerien im Hamburger Schanzen- und Karoviertel zum 2ten Mal ihre Ateliers, Werkstätten und Studios und präsentierten ihre Kunst. WebSite dazu von IconScreen. Gezeigt wurden alle Sparten der bildenden Kunst, von Malerei über Fotografie bis hin zu Installationen, Medienkunst, Illustration oder Aktionen. Weiterlesen...

Unter dem Claim „Zukunftsplan Altona“ soll eine Perspektive für die räumliche Entwicklung der drei Stadtteile Altona-Altstadt, Altona-Nord und Sternschanze gesucht werden. Die innerhalb des Contentmanagement-Systems der Stadt Hamburg „CoreMedia“ erstellte WebSite begleitet diesen ergebnisoffenen Prozess. IconScreen erstellte die WebSite und pflegt die aktuellen Inhalte. Weiterlesen...

Für das Entwicklungsquartier Altona-Altstadt wird eine informative WebSite gestaltet und umgesetzt. IconScreen entwickelt ein modernes übersichtliches „Look and Feel“ für die WebSite. Ein Redaktionssystem zur redaktionellen Betreuung relevanter Inhalte wird integriert. Weiterlesen...

Der Hannoversche Bahnhof als Deportationsbahnhof in der Nazi-Zeit wurde in der Geschichte Hamburgs bisher kaum thematisiert. Eine Ausstellung im Auftrag der Kulturbehörde, in Zusammenarbeit mit der Forschungsstelle für Zeitgeschichte in Hamburg und der KZ-Gedenkstätte Neuengamme, nahm sich diesem Thema an. Die von uns erstellte und betreute Website bietet die Geschichte der Deportationen von Juden, Roma und Sinti aus Hamburg 1940–1945 und begleitet die Ausstellung, auch mit multimedialen Elementen. Weiterlesen...

Für die WebSite des Julius-Leber-Forums der Friedrich-Ebert-Stiftung setzte IconScreen den grafischen und inhaltlichen Relaunch um. Wir freuen uns diese Aufgabe erneut zu übernehmen. Ausgehend vom Corporate Design und den Bedürfnissen des Hamburger Büros, wird das zentrale Angebot des Julius-Leber-Forums visualisiert: „Öffentlicher Dialog von Gesellschaft und Politik“. Weiterlesen...

Das Stadtteilbüro ist zentraler Anlaufpunkt für alle Fragen und Anregungen rund um den Entwicklungsraum Billstedt-Horn. Hier bietet der neue TouchScreen übersichtliche Informationen mit anschaulichen Fotos und Texten die zum durchlicken einladen. IconScreen machte das ScreenDesign unter Berücksichtigung der Gestaltungsrichtlinien der Stadt Hamburg. Weiterlesen...

St. Pauli und die Sternschanze sind Hamburgs hot spot für Existenzgründungen. Die steg bietet jungen Unternehmen und Start-ups hier günstige Gewerberäume zu flexiblen Konditionen an. Diese innovativen Gründerzentren werden mit ausführlichen Bilddokumentationen und positiven Stimmen der Gründer vorgestellt. IconScreen gestaltet den Relaunch der WebSite. Weiterlesen...

Rund 30 Flyer – ein übergreifendes Thema: Öffentlicher Dialog von Gesellschaft und Politik. Eingeladen wird zu Diskussionen, Ausstellungen, Kompetenztrainings oder Seminaren. Viele der Einladungen sind von IconScreen gestaltet. Weiterlesen...

Billstedt-Horn ist mit rund 105.000 Einwohnern eine Großstadt in der Metropole Hamburg. Das Entwicklungskonzept Billstedt-Horn beschreibt, mit welchen Maßnahmen sich Billstedt und Horn in den kommenden Jahren zu lebenswerteren Stadtteilen entwickeln sollen. Weiterlesen...

Kommunikation für Unternehmen, Organisationen und Standorte: Wir gestalteten den Internet-Auftritt für die in Hamburg ansässige PR-Agentur SUPERURBAN. Weiterlesen...

Bürger Beteiligungsverfahren über die Verlegung der Wilhelmsburger Reichsstraße in Hamburg auf die Bahntrasse, den Bau einer Hafenquerspange sowie eine Gesamtkonzeption für den Verkehr auf den Hamburger Elbinseln. Der begleitende Internetauftritt wurde von uns erstellt. Weiterlesen...

Kreativwerkstatt für Jugendliche zum Thema Europa: IconScreen entwarf die WebSite und leitete die Medienwerkstatt zur Dokumentation der Ergebnisse im Internet. Die Jugendlichen begleiteten die Workshops mit Kamera und Kommentaren und hielten den Ablauf der Projekttage mit Video, Blog und Twitter fest. Mit vorbereiteten WordPress Templates füllte sich die Projekt-WebSite schnell mit Inhalten. Weiterlesen...

WEISSENBURG Industrie-Technik und Maschinenbau: Das Unternehmen ist ein Generalanbieter in den Bereichen Fördertechnik, Automatisierungstechnik und Fahrerlose Transportsysteme (FTS). Auf der HomePage sind diese Projektgruppen plakativ in Szene gesetzt. Ansprechende Fotografien und kurze Anreißer-Texte (Teaser) machen neugierig auf die weiteren Inhalte. Weiterlesen...

Flyer reloaded: Im Jahr 2009 gibt es wieder viele schöne Einladungs-Flyer für das Julius-Leber-Forum. Entstanden sind auch neue Reihen mit einem spezifischen Erscheinungsbild wie „Der politische Film“, zu denen regelmäßig eingeladen wird. Weiterlesen...

Die zentrale Beratungsstelle für Betriebsübernahmen ist der neue kompetente Service für Handwerksbetriebe mit Übergabeabsichten. Für den „Übergabelotsen“, ein ESF-Projekt der Handwerkskammer Hamburg, gestaltete und erstellte IconScreen eine eigenständige Internetseite. Weiterlesen...

Im Wilhelmsburger Gründerzeitquartier Reiherstiegviertel wird ein wahres Vorzeigeprojekt für neue Wohnformen und die Nutzung regenerativer Ressourcen gebaut. Mit Unterstützung der internationalen Bauausstellung (IBA) entsteht hier ein ökologisches Projekt, mit genossenschaftlichem Wohnen und Eigentumsbau. Für die Vermarktung der Wohneinheiten gestaltete IconScreen die WebSite. Weiterlesen...

Die PÖYRY Energy GmbH Hamburg ist eine Tochtergesellschaft des weltweit tätigen PÖYRY Konzerns. Die Schwerpunkte sind Beratungs- und Planungsleistungen für Erneuerbare Energien, Strom & Wärme und Technisches Consulting. Angelehnt an das Coporate Design der PÖYRY Group präsentiert sich die Unternehmensdarstellung im zeitgemäßen Look. Weiterlesen...

Unter dem Motto „Zwischen Meer und Metropole“ vermarkten sechs Regionen aus dem Kreis Steinburg gemeinsam ihre Wohnbaugebiete. Die WebSite ist in Anlehnung an die bestehende Broschüre gestaltet. Entstanden ist ein gelungener Medien-Mix unter einem Dach. Weiterlesen...

Die meisten Fotos sind Erinnerungsfotos: In diesem Sinne zeigen verschiedene Autoren aus Berlin und Hamburg ihre Fotografien. Bookmarks stellen andere interessante Photoblogs und Ausstellungstermine vor. Die Idee entstand zusammen mit Karsten Hein, die Gestaltung und Umsetzung übernahm IconScreen. Weiterlesen...

Die Immobilie „Villaggio Alstertal“ bietet der Generation 50plus Wohnen im Grünen in angenehmer, ruhiger Atmosphäre. Die von SUPERURBAN entwickelte Marke wurde von IconScreen auf die Internetseite übertragen. Weiterlesen...

Mit einem Sortiment von über 100.000 Antikörpern und relevanten Produkten zählt die Acris Antibodies GmbH zu den führenden Anbietern in Deutschland, Österreich und der Schweiz. IconScreen lieferte das Design und den Template-Set für die Magento eCommerce Software. Und erstellte ein Muster für den monatlich erscheinenden PDF-Newsletter. Weiterlesen...

Die Acris Antibodies GmbH zählt zu den führenden Anbietern von Antikörpern: Korrespondierend mit der Gestaltung der WebSite entsteht ein neues Erscheinungsbild für ein Newsletter-Magazin, Datenblätter, Jubiläumspostkarte und Packungsaufkleber. Für die laufende Produktion erhält der Kunde Design-Vorlagen in die hineingearbeitet werden kann. Weiterlesen...

Das Julius-Leber-Forum der Friedrich-Ebert-Stiftung präsentierte zusammen mit dem Hamburger Schulmuseum die multimediale Ausstellung „Anne Frank. Ein Mädchen aus Deutschland“, begleitet von einem facettenreichen Rahmenprogramm. Das umfangreiche Programmheft wurde von uns gestaltet. Weiterlesen...

WebDesign und Grafik für das erste Gameentwickler-Gründerhaus in Deutschland: GameCity Port, Hamburg. Büros zu günstigen Konditionen für junge Selbstständige aus der Games-Szene. Das Konzept des GameCity Port basiert auf drei Bausteinen: Kleinstbürofläche, eine günstige Miete und flexible Vertragsbedingungen. Weiterlesen...
Zwei Unternehmen – ein gemeinsamer Internetauftritt: zum einen das unabhängige Beratungs- und Dienstleistungsunternehmen für Gebäudesanierung, Umweltanalytik und Begutachtung. Zum anderen die Analytik von Schadstoffen in Baustoffen, Materialuntersuchungen, Bodenproben und Luftmessungen. Die gestalterische Lösung dazu entwarf IconScreen. Weiterlesen...

Die Schweißtechnische Lehr- und Versuchsanstalt Nord, kurz SLV Nord, ist kompetenter Partner auf allen Gebieten der Schweißtechnik. Mit den neuen Werkstätten im ELBCAMPUS ist ein neues Zeitalter angebrochen: Langjährige Erfahrung in der Schweißerausbildung trifft hier auf technische Rahmenbedingungen, die in Norddeutschland einmalig sind. Die zahlreichen Aus- und Weiterbildungsangebote finden sich auf der ständig weiterentwickelten WebSite. Weiterlesen...

Die Landesinnung der Gebäudereiniger Hamburg / MV setzt sich für die Anliegen ihrer Mitglieder ein: insbesondere um wirtschaftliche Aspekte und Ausbildungsfragen. Und sie stellt Kontakte zu Institutionen und politischen Gremien her und bietet arbeitsrechtliche Beratung an. Die Innung und ihre Aufgaben werden auf der WebSite informativ vorgestellt. Weiterlesen...

Das Intranet definiert die effektive, interne Kommunikation: Information soll klar und präzise dargestellt und einfach abrufbar sein. IconScreen entwickelte erneut ein kommunikationsförderndes WebDesign für das Intranet des Landkreis Osnabrück. Weiterlesen...

Puppe Hoffnung ist Theater, das denkt, fühlt und unterhält – eine Verbindung aus Schauspiel, Musik und Bildender Kunst. Überleben in den Arbeits- und Vernichtungslagern Hamburg-Neuengamme und Sobibór, Polen. Dokumentarisches und Fiktionales. Diese ungewöhnliche Inszenierung wird auf der WebSite vorgestellt. Weiterlesen...

Kennen Sie das? Sie suchen einen guten Handwerker und wissen nicht, an wen Sie sich wenden sollen: Mit dem Online-Bewertungssystem der Handwerkskammer Hamburg, dem HandwerkTest, können Sie unter rund 15.000 registrierten Mitgliedsbetrieben nach dem für Sie richtigen suchen. Weiterlesen...

Parallel zum Online-Bewertungssystem der Handwerkskammer Hamburg, dem HandwerkTest, wurde das Corporate Design entwickelt. Logo und Flyer. Der Flyer wurde tausendfach in Hamburg über die Handwerker selbst, die Hamburger Sparkasse und andere öffentliche Orte verteilt. Weiterlesen...

Das Schanzenviertel ist eines der attraktivsten Stadtteile Hamburgs. Das Neubauprojekt „Schulterblatt 25“ der steg Hamburg soll vorrangig Bewohnern mit Kindern aus dem Stadtteil familiengerechtes Wohnen ermöglichen. Weiterlesen...

VITROHM – ein Unternehmen der Elektrotechnik: Als einer der führenden Hersteller von elektrischen Widerständen, beschäftigt VITROHM über 200 Mitarbeiter. Es galt, das traditionsreiche Unternehmen modern und ansprechend zu präsentieren. Die Gestaltung sollte klar und übersichtlich sein. Dazu entwickelten wir ein komplett neues WebDesign. Weiterlesen...

In St. Pauli entstand das Karostar Musikhaus mit 33 Büros, drei Produktionsstudios und Läden für junge Unternehmen aus der Hamburger Musikwirtschaft. Das Musikhaus bietet Gründern günstige Startkonditionen und hat sich zu einem Knotenpunkt in Hamburgs Musikszene entwickelt. Der Standort St. Pauli ist für das neue Gebäude ideal: Hier konzentrieren sich mehr als 100 kleine Betriebe aus der Musikszene. Dieses enge Netz soll stabilisiert und gestärkt werden. Weiterlesen...

IconScreen entwickelte eine einfach gehaltene Design-Struktur für das on- und offline erscheinende Magazin „Schanzen-Info“. Mit diesem will die steg Hamburg auf ihre Arbeit aufmerksam machen und eine Plattform zur kontroversen Diskussion der Probleme des Stadtviertels bieten. Weiterlesen...

Cross-Media für das Schanzenviertel im 4ten Jahr. Die Stadterneuerungs- und Stadtentwicklungsgesellschaft Hamburg – kurz steg – versucht, soziale Prozesse durch Kommunikation, Informationen und Aktionen zu unterstützen. Weiterlesen...

Am Anfang war die WebSite, dann folgten die ersten Flyer – der Beginn einer wunderbaren Verbindung: Fortan entstanden jährlich etliche von IconScreen gestaltete Flyer. Sie locken Besucher an zu den Podiumsdiskussionen, Vortragsveranstaltungen und Gesprächsrunden des Julius-Leber-Forums. Aktuelle politische und gesellschaftliche Fragen stehen dabei im Zentrum. Weiterlesen...

Unsere Projekte aus der Schatzkiste der Jahre 1997 – 2004 folgen demnächst hier, versprochen! Wir gestalten ja seit 1997 Internetseiten und bieten komplexe Kommunikationslösungen für Onlinemedien. Sind also alte Hasen. (Wir kennen auch noch MagicVillage, Newsgroups und das rasselnde Geräusch beim Starten des Modems...) Weiterlesen...